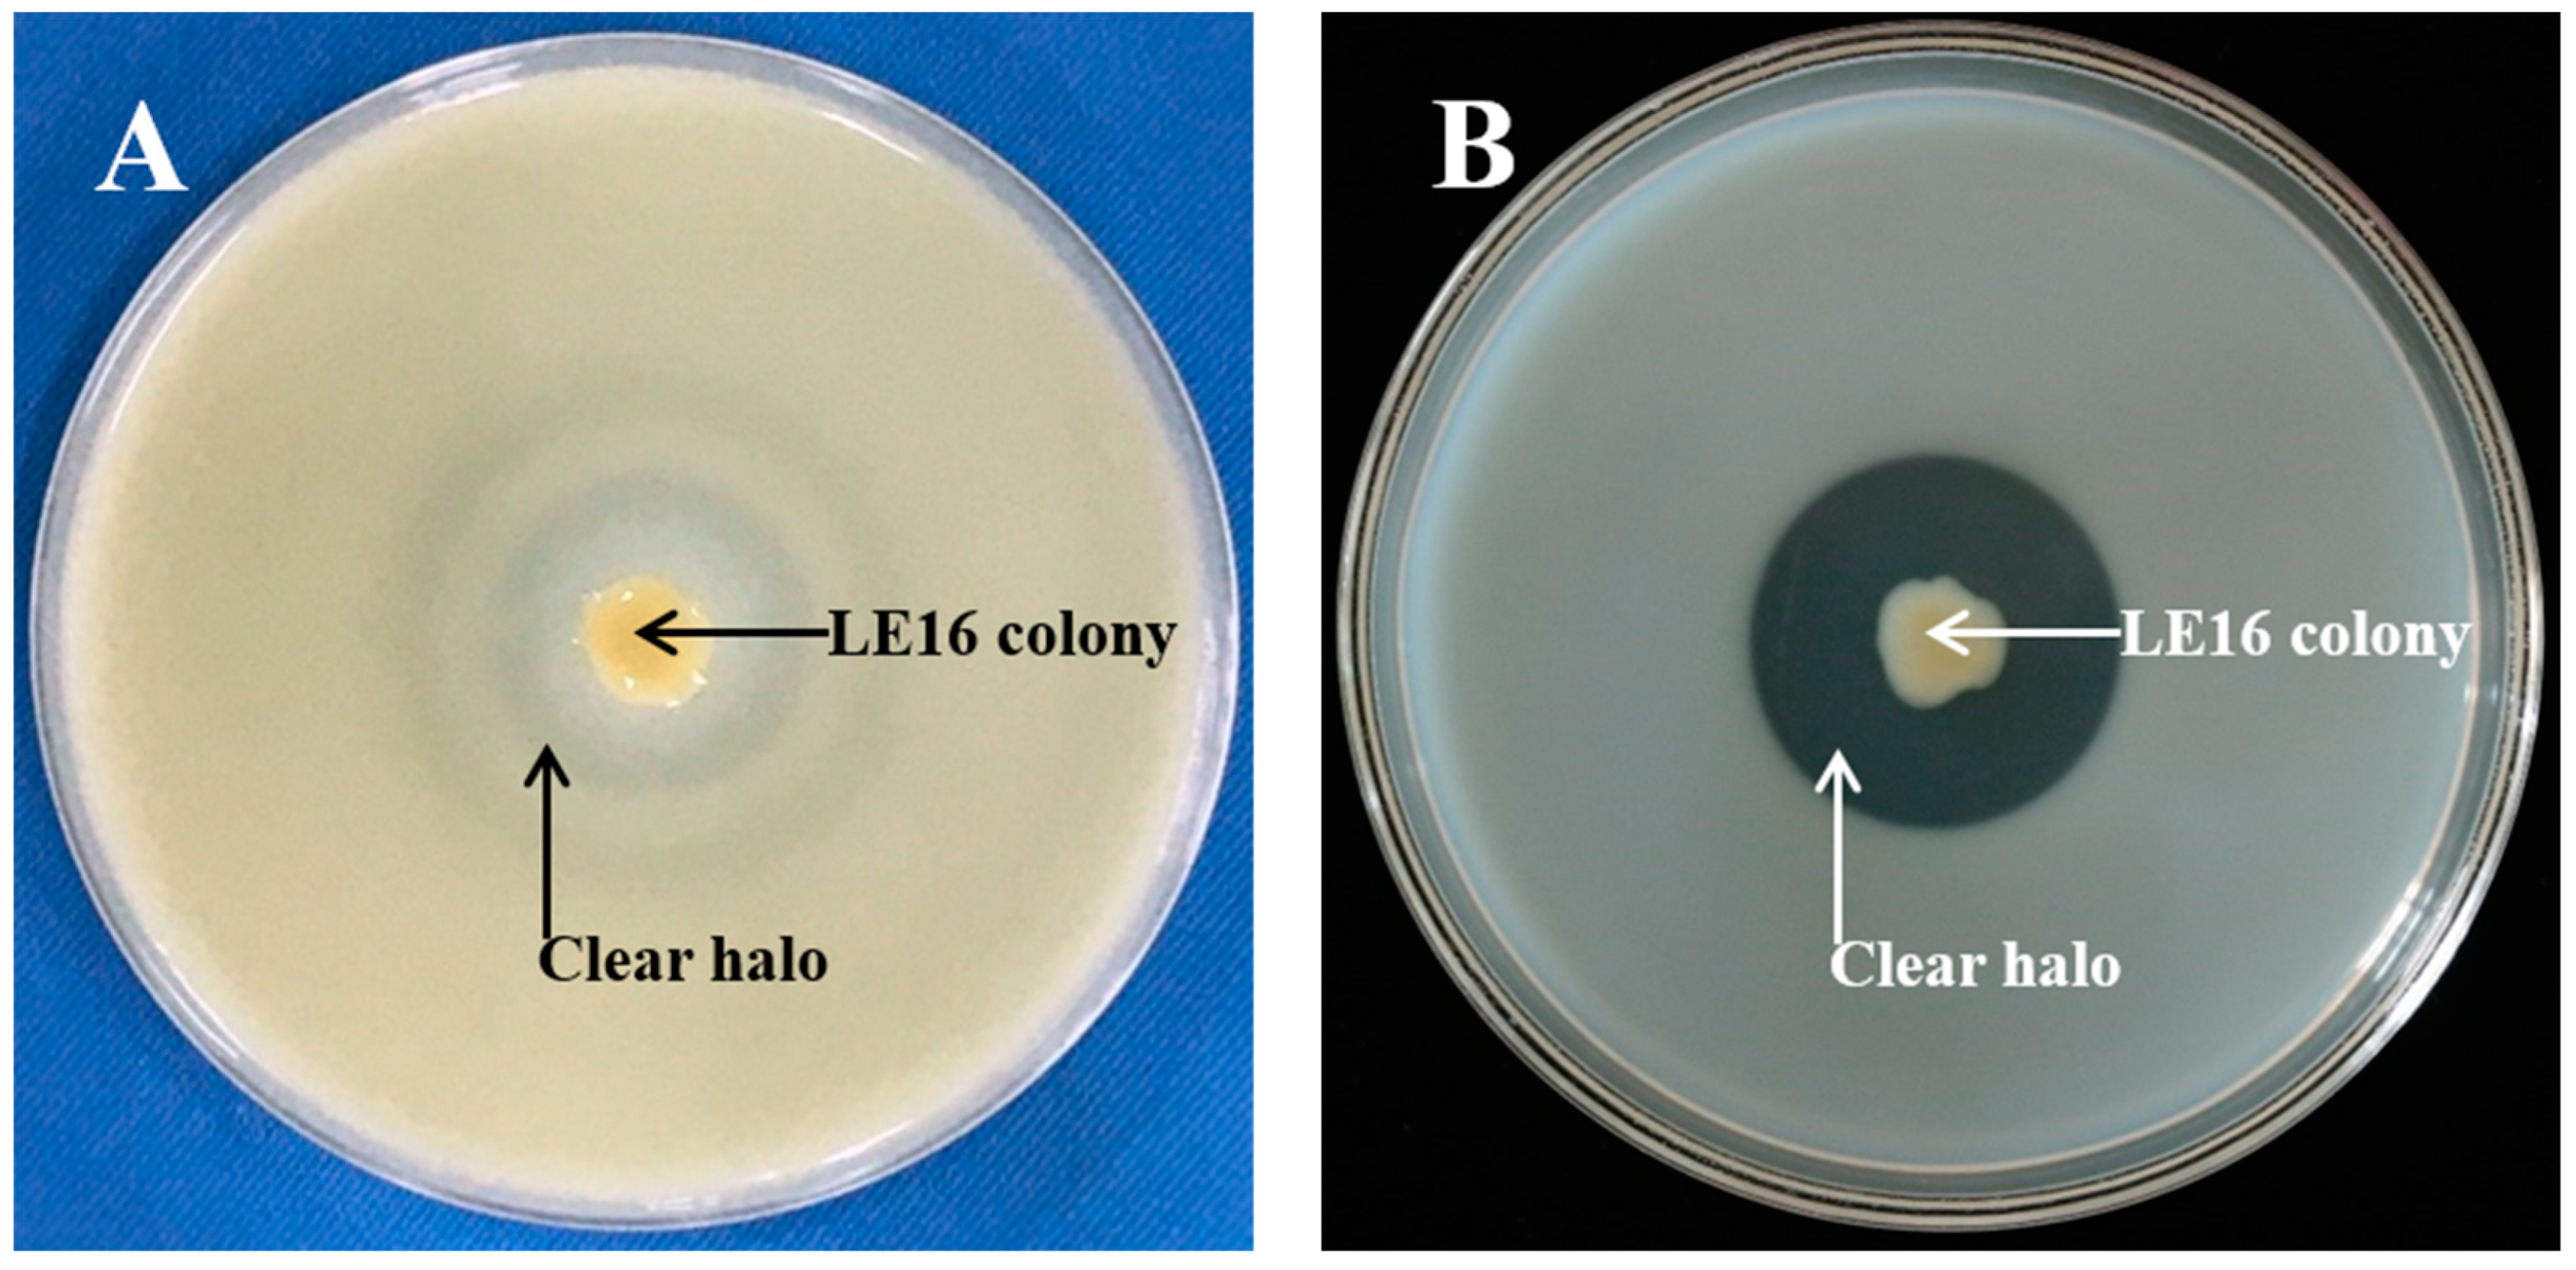
Agronomy 13 01453 g001 Agronomy 13 01453 g001

Enhancement of Soil Available Nutrients and Crop Growth in Sustainable Agriculture by a Biocontrol Bacterium Lysobacter enzymogenes LE16: Preliminary Results in Controlled Conditions
Abstract
1. Introduction
2. Materials and Methods
2.1. Preparation of Bacterial Inoculant
2.2. Plate Culture Experiment
2.3. Liquid Culture Experiment
2.3.1. Hydrolysis of Lecithin in Liquid Culture Solutions
2.3.2. Hydrolysis of Protein in Liquid Culture Solutions
2.4. Soil incubation Experiment
2.5. Greenhouse Pot Experiment
2.6. Data Treatments
3. Results
3.1. Hydrolysis of Lecithin and Protein by L. enzymogenes LE16
3.2. Extracellular Hydrolytic Enzymes Produced by L. enzymogenes LE16
3.3. Changes in Soil P and N after Inoculation with L. enzymogenes LE16
3.4. Effects of the Test Bacterial Inoculant on Lettuce and Pepper Performances in the Greenhouse Pot Experiment
3.5. Effects of the Test Bacterial Inoculant on Plant-Grown Soil Properties
4. Discussion
5. Conclusions
Author Contributions
Funding
Data Availability Statement
Conflicts of Interest
References
- Mathew, R.P.; Feng, Y.; Githinji, L.; Ankumah, R.; Balkcom, K.S. Impact of No-Tillage and Conventional Tillage Systems on Soil Microbial Communities. Appl. Environ. Soil Sci. 2012, 2012, 548620. [Google Scholar] [CrossRef]
- Mertz, O.; Padoch, C.; Fox, J.; Cramb, R.A.; Leisz, S.J.; Lam, N.T.; Viên, T.D. Swidden Change in Southeast Asia: Understanding Causes and Consequences. Hum. Ecol. 2009, 37, 259–264. [Google Scholar] [CrossRef]
- Ziegler, A.D.; Fox, J.M.; Webb, E.L.; Padoch, C.; Leisz, S.J.; Cramb, R.A.; Mertz, O.; Bruun, T.B.; Vien, T.D. Recognizing Contemporary Roles of Swidden Agriculture in Transforming Landscapes of Southeast Asia. Conserv. Biol. 2011, 25, 846–848. [Google Scholar] [CrossRef]
- Yang, X.; Sui, P.; Shen, Y.; Gerber, J.S.; Wang, D.; Wang, X.; Dai, H.; Chen, Y. Sustainability Evaluation of the Maize–Soybean Intercropping System and Maize Monocropping System in the North China Plain Based on Field Experiments. Agronomy 2018, 8, 268. [Google Scholar] [CrossRef]
- Atieno, M.; Herrmann, L.; Nguyen, H.T.; Phan, H.T.; Nguyen, N.K.; Srean, P.; Than, M.M.; Zhiyong, R.; Tittabutr, P.; Shutsrirung, A.; et al. Assessment of Biofertilizer Use for Sustainable Agriculture in the Great Mekong Region. J. Environ. Manag. 2020, 275, 111300. [Google Scholar] [CrossRef] [PubMed]
- Barrett, G.; Marsh, S. Challenges for Contemporary Extension: The Case of Biofertiliser in Vietnam. Retrieved from The Regional Institute. 2001. Available online: http://www.regional.org.au/au/apen/2001/non-refereed/BarrettG.htm (accessed on 12 May 2021).
- Zhen, L.; Zoebisch, M.A.; Chen, G.; Feng, Z. Sustainability of Farmers’ Soil Fertility Management Practices: A case study in the North China Plain. J. Environ. Manag. 2006, 79, 409–419. [Google Scholar] [CrossRef]
- Cordell, D.; Drangert, J.-O.; White, S. The Story of Phosphorus: Global Food Security and Food for Thought. Glob. Environ. Chang. 2009, 19, 292–305. [Google Scholar] [CrossRef]
- Cordell, D.; White, S. Peak Phosphorus: Clarifying the Key Issues of a Vigorous Debate about Long-Term Phosphorus Security. Sustainability 2011, 3, 2027–2049. [Google Scholar] [CrossRef]
- Jate, M. Long-term Effect of Balanced Mineral Fertilizer Application on Potato, Winter rye, and Oat Yields; Nutrient Use Efficiency; and Soil Fertility. Arch. Agron. Soil Sci. 2010, 56, 421–432. [Google Scholar] [CrossRef]
- Lindsay, W.L.; Vlek, P.L.G.; Chien, S.H. Phosphate Minerals. In Minerals in Soil Environment, 2nd ed.; American Society of Agronomy: Madison, WI, USA, 1989; pp. 1089–1130. [Google Scholar]
- Norrish, K.; Rosser, H. Mineral phosphate. In Soils: An Australian Viewpoint; Academic Press: Melbourne, VIC, Australia; CSIRO: London, UK, 1983; pp. 335–361. [Google Scholar]
- Romanyà, J.; Arco, N.; Solà-Morales, I.; Armengot, L.; Sans, F.X. Carbon and Nitrogen Stocks and Nitrogen Mineralization in Organically Managed Soils Amended with Composted Manures. J. Environ. Qual. 2012, 41, 1337–1347. [Google Scholar] [CrossRef]
- Sylvia, D.M.; Fuhrmann, J.J.; Hartel, P.G.; Zuberer, D.A. (Eds.) Principles and Applications of Soil Microbiology; No. QR111 S674 2005; Pearson Prentice Hall: Upper Saddle River, NJ, USA, 2005. [Google Scholar]
- Menezes-Blackburn, D.; Giles, C.; Darch, T.; George, T.S.; Blackwell, M.; Stutter, M.; Shand, C.; Lumsdon, D.; Cooper, P.; Wendler, R.; et al. Opportunities for Mobilizing Recalcitrant Phosphorus from Agricultural Soils: A review. Plant Soil 2018, 427, 5–16. [Google Scholar] [CrossRef]
- Clarholm, M.; Skyllberg, U.; Rosling, A. Organic Acid Induced Release of Nutrients from Metal-Stabilized Soil Organic Matter—the Unbutton Model. Soil Biol. Biochem. 2015, 84, 168–176. [Google Scholar] [CrossRef]
- Knicker, H. Soil organic N—An under-rated Player for C Sequestration in Soils? Soil Biol. Biochem. 2011, 43, 1118–1129. [Google Scholar] [CrossRef]
- Vranova, V.; Rejsek, K.; Formanek, P. Proteolytic Activity in Soil: A Review. Appl. Soil Ecol. 2013, 70, 23–32. [Google Scholar] [CrossRef]
- Christensen, P.; Cook, F.D. Lysobacter, a New Genus of Nonfruiting, Gliding Bacteria with a High Base Ratio. Int. J. Syst. Bacteriol. 1978, 28, 367–393. [Google Scholar] [CrossRef]
- Chen, D.; Yang, H.; Huang, J.; Yuan, L. Lysobacter enzymogenes LE16 Autolysates Have Potential as Biocontrol Agents—Lysobacter sp. Autolysates as Biofungicide. J. Appl. Microbiol. 2020, 129, 1684–1692. [Google Scholar] [CrossRef]
- Fürnkranz, M.; Adam, E.; Müller, H.; Grube, M.; Huss, H.; Winkler, J.; Berg, G. Promotion of Growth, Health and Stress Tolerance of Styrian Oil Pumpkins by Bacterial Endophytes. Eur. J. Plant Pathol. 2012, 134, 509–519. [Google Scholar] [CrossRef]
- Laborda, P.; Ling, J.; Chen, X.; Liu, F. ACC Deaminase from Lysobacter gummosus OH17 Can Promote Root Growth in Oryza sativa Nipponbare Plants. J. Agric. Food Chem. 2018, 66, 3675–3682. [Google Scholar] [CrossRef] [PubMed]
- Pikovskaya, R.I. Mobilization of Phosphorus in Soil in Connection with Vital Activity of Some Microbial Species. Mikrobiologiya 1948, 17, 362–370. [Google Scholar]
- Odhiambo, B.O.; Xu, G.; Qian, G.; Liu, F. Evidence of an Unidentified Extracellular Heat-Stable Factor Produced by Lysobacter enzymogenes (OH11) that Degrade Fusarium graminearum PH1 Hyphae. Curr. Microbiol. 2017, 74, 437–448. [Google Scholar] [CrossRef]
- Ji, G.H. Advances in The Studies on Lysobacter sp. and Their Effects on Biological Control of Plant Diseases. J. Yunnan Agric. Univ. 2011, 26, 124–130. [Google Scholar] [CrossRef]
- Pansu, M.; Gautheyrou, J. Handbook of Soil Analysis: Mineralogical, Organic and Inorganic Methods; Springer Science & Business Media: Berlin/Heidelberg, Germany, 2007. [Google Scholar]
- Tabatabai, M.A.; Bremner, J.M. Use of p-nitrophenyl Phosphate for Assay of Soil Phosphatase Activity. Soil Biol. Biochem. 1969, 1, 301–307. [Google Scholar] [CrossRef]
- Sun, J.L.; Liang, X.H.; Chen, S.L.; Bin Fan, Y. Effect of Folin Reagent from Different Sources on Protease Determination. Adv. Mater. Res. 2013, 662, 305–308. [Google Scholar] [CrossRef]
- Yao, L.X.; Wu, Z.S.; Zheng, Y.Y.; Kaleem, I.; Li, C. Growth Promotion and Protection Against Salt Stress by Pseudomonas putida Rs-198 on Cotton. Eur. J. Soil Biol. 2010, 46, 49–54. [Google Scholar] [CrossRef]
- Chen, H.Y.; Quan, W.X.; Liu, H.Y.; Ding, G.J. Efects of Suillus luteus and S. bovinus on the Physiological Response and Nutrient Absorption of Pinus massoniana Seedlings under Phosphorus Deficiency. Plant Soil. 2022, 471, 577–590. [Google Scholar] [CrossRef]
- Yin, J.; Yuan, L.; Huang, J. New Functions of Ceriporia lacerata HG2011: Mobilization of Soil Nitrogen and Phosphorus and Enhancement of Yield and Quality of Ketchup-Processing Tomato. J. Agric. Food Chem. 2021, 69, 4056–4063. [Google Scholar] [CrossRef] [PubMed]
- Zhang, S.; Zhang, R. Effects of Microwave Pretreatment of Apple Raw Material on the Nutrients and Antioxidant Activities of Apple Juice. J. Food Process. 2014, 2014, 824050. [Google Scholar] [CrossRef]
- Rangana, S. Handbook of Analysis and Quality Control for Fruit and Vegetable Products; Tata McGraw Hill Publishing Company Ltd.: New Delhi, India, 2010. [Google Scholar]
- Miller, G.L. Use of Dinitrosalicylic Acid Reagent for Determination of Reducing Sugar. Anal. Chem. 1959, 31, 426–428. [Google Scholar] [CrossRef]
- Vance, E.; Brookes, P.; Jenkinson, D. Microbial Biomass Measurements in Forest Soils: The Use of the Chloroform Fumigation-Incubation Method in Strongly Acid Soils. Soil Biol. Biochem. 1987, 19, 697–702. [Google Scholar] [CrossRef]
- López-Bellido, L.; López-Bellido, R.J.; Redondo, R. Nitrogen Efficiency in Wheat under Rainfed Mediterranean Conditions as Affected by Split Nitrogen Application. Field Crop. Res. 2005, 94, 86–97. [Google Scholar] [CrossRef]
- Maseko, S.; Dakora, F. Rhizosphere Acid and Alkaline Phosphatase Activity as a Marker of P Nutrition in Nodulated Cyclopia and Aspalathus Species in the Cape fynbos of South Africa. S. Afr. J. Bot. 2013, 89, 289–295. [Google Scholar] [CrossRef]
- Annaheim, K.; Doolette, A.; Smernik, R.; Mayer, J.; Oberson, A.; Frossard, E.; Bünemann, E. Long-term Addition of Organic Fertilizers Has Little Effect on Soil Organic Phosphorus as Characterized by 31P NMR Spectroscopy and Enzyme Additions. Geoderma 2015, 257–258, 67–77. [Google Scholar] [CrossRef]
- Jarosch, K.A.; Doolette, A.L.; Smernik, R.J.; Tamburini, F.; Frossard, E.; Bünemann, E.K. Characterisation of Soil Organic Phosphorus in NaOH-EDTA Extracts: A Comparison of 31P NMR Spectroscopy and Enzyme Addition Assays. Soil Biol. Biochem. 2015, 91, 298–309. [Google Scholar] [CrossRef]
- George, T.S.; Simpson, R.J.; Gregory, P.J.; Richardson, A.E. Differential Interaction of Aspergillus niger and Peniophora lycii Phytases with Soil Particles Affects the Hydrolysis of Inositol Phosphates. Soil Biol. Biochem. 2007, 39, 793–803. [Google Scholar] [CrossRef]
- Nannipieri, P.; Giagnoni, L.; Landi, L.; Renella, G. Role of Phosphatase Enzymes in Soil. In Phosphorus in Action; Springer: Berlin/Heidelberg, Germany, 2011; pp. 215–243. [Google Scholar]
- Cosgrove, D.J.; Irving, G.C.J. Inositol Phosphates: Their Chemistry, Biochemistry, and Physiology; Elsevier Science & Technology: Amsterdam, The Netherlands, 1980; Volume 4, p. 191. [Google Scholar]
- Bai, Y.; Xiang, Q.; Zhao, K.; Yu, X.; Chen, Q.; Ma, M.; Jiang, H.; Zhang, X.P.; Penttinen, P.; Gu, Y.F. Plant and Soil Development Cooperatively Shaped the Composition of the phoD-Harboring Bacterial Community Along the Primary Succession in the Hailuogou Glacier Chronosequence. mSystems 2020, 5, e00475-20. [Google Scholar] [CrossRef]
- Wei, X.; Hu, Y.; Razavi, B.S.; Zhou, J.; Shen, J.; Nannipieri, P.; Wu, J.; Ge, T. Rare Taxa of Alkaline Phosphomonoesterase-Harboring Microorganisms Mediate Soil Phosphorus Mineralization. Soil Biol. Biochem. 2019, 131, 62–70. [Google Scholar] [CrossRef]
- Wu, M.Y.; Wei, Q.; Xu, L.; Li, H.Z.; Oelmüller, R.; Zhang, W.Y. Piriformospora Indica Enhances Phosphorus Absorption by Stimulating Acid Phosphatase Activities and Organic Acid Accumulation in Brassica napus. Plant Soil 2018, 432, 333–344. [Google Scholar] [CrossRef]
- Chen, D.; Huang, J.; Yuan, L. A New Function of the Biocontrol Bacterium Lysobacter enzymogenes LE16 in the Mineralization of Soil Organic Phosphorus. Plant Soil 2019, 442, 299–309. [Google Scholar] [CrossRef]
- Von Tigerstrom, R.G. Production of Two Phosphatases by Lysobacter enzymogenes and Purification and Characterization of the Extracellular Enzyme. Appl. Environ. Microbiol. 1984, 47, 693–698. [Google Scholar] [CrossRef]
- Bais, H.P.; Park, S.-W.; Weir, T.L.; Callaway, R.M.; Vivanco, J.M. How Plants Communicate Using the Underground Information Superhighway. Trends Plant Sci. 2004, 9, 26–32. [Google Scholar] [CrossRef]
- Condron, L.M.; Turner, B.L.; Cade-Menun, B.J. Chemistry Dynamics of Soil Organic Phosphorus. In Phosphorus: Agri-Culture the Environment; Sims, J.T., Sharpley, A.N., Eds.; American Society of Agronomy: Madison, WI, USA, 2005; pp. 87–121. [Google Scholar]
- Dinkelaker, B.; Marschner, H. In vivo Demonstration of Acid Phosphatase Activity in the Rhizosphere of Soil-Grown Plants. Plant Soil 1992, 144, 199–205. [Google Scholar] [CrossRef]
- Nakas, J.; Gould, W.; Klein, D. Origin and Expression of Phosphatase Activity in A Semi-Arid Grassland Soil. Soil Biol. Biochem. 1987, 19, 13–18. [Google Scholar] [CrossRef]
- Sakurai, M.; Wasaki, J.; Tomizawa, Y.; Shinano, T.; Osaki, M. Analysis of Bacterial Communities on Alkaline Phosphatase Genes in Soil Supplied with Organic Matter. Soil Sci. Plant Nutr. 2008, 54, 62–71. [Google Scholar] [CrossRef]
- Jan, M.; Roberts, P.; Tonheim, S.; Jones, D. Protein Breakdown Represents A Major Bottleneck in Nitrogen Cycling in Grassland Soils. Soil Biol. Biochem. 2009, 41, 2272–2282. [Google Scholar] [CrossRef]
- Weintraub, M.N.; Schimel, J.P. Seasonal Protein Dynamics in Alaskan arctic Tundra Soils. Soil Biol. Biochem. 2005, 37, 1469–1475. [Google Scholar] [CrossRef]
- Ladd, J.; Butler, J. Short-Term Assays of Soil Proteolytic Enzyme Activities Using Proteins and Dipeptide Derivatives as Substrates. Soil Biol. Biochem. 1972, 4, 19–30. [Google Scholar] [CrossRef]
- Geisseler, D.; Horwath, W.R. Regulation of Extracellular Protease Activity in Soil in Response to Different Sources and Concentrations of Nitrogen and Carbon. Soil Biol. Biochem. 2008, 40, 3040–3048. [Google Scholar] [CrossRef]
- Kannapiran, E.; Ravindran, J. Dynamics and Diversity of Phosphate Mineralizing Bacteria in the Coral Reefs of Gulf of Mannar. J. Basic Microbiol. 2011, 52, 91–98. [Google Scholar] [CrossRef]
- Zhou, M.-Y.; Chen, X.-L.; Zhao, H.-L.; Dang, H.-Y.; Luan, X.-W.; Zhang, X.-Y.; He, H.-L.; Zhou, B.-C.; Zhang, Y.-Z. Diversity of Both the Cultivable Protease-Producing Bacteria and Their Extracellular Proteases in the Sediments of the South China Sea. Microb. Ecol. 2009, 58, 582–590. [Google Scholar] [CrossRef]
- Ahmad, F.; Ahmad, I.; Khan, M. Screening of Free-Living Rhizospheric Bacteria for Their Multiple Plant Growth Promoting Activities. Microbiol. Res. 2008, 163, 173–181. [Google Scholar] [CrossRef]
- Mazid, M.; Khan, T.A. Future of Bio-fertilizers in Indian agriculture: An Overview. Int. J. Agric. Food Res. 2014, 3, 10–23. [Google Scholar] [CrossRef]
- Mahanty, T.; Bhattacharjee, S.; Goswami, M.; Bhattacharyya, P.; Das, B.; Ghosh, A.; Tribedi, P. Biofertilizers: A Potential Approach for Sustainable Agriculture Development. Environ. Sci. Pollut. Res. 2017, 24, 3315–3335. [Google Scholar] [CrossRef] [PubMed]
- Schütz, L.; Gattinger, A.; Meier, M.; Müller, A.; Boller, T.; Mäder, P.; Mathimaran, N. Improving Crop Yield and Nutrient Use Efficiency via Biofertilization—A Global Meta-analysis. Front. Plant Sci. 2018, 8, 2204. [Google Scholar] [CrossRef] [PubMed]
- Wilujeng, R.; Ichriani, G.I.; Fahrunsyah, F.; Nuraini, Y.; Handayanto, E. The Possible Use of Coal Fly Ash and Phosphate-solubilizing Fungi for Improving the Availability of P and Plant Growth in Acid Soil. J. Degrad. Min. Lands Manag. 2020, 8, 2471–2480. [Google Scholar] [CrossRef]
- Bhatt, K.; Maheshwari, D.K. Bacillus megaterium Strain CDK25, a Novel Plant Growth Promoting Bacterium Enhances Proximate Chemical and Nutritional Composition of Capsicum annuum L. Front. Plant Sci. 2020, 11, 1147. [Google Scholar] [CrossRef]
- Pandya, N.D.; Desai, P.V.; Jadhav, H.P.; Sayyed, R.Z. Plant Growth Promoting Potential of Aspergillus sp. NPF7, Isolated from Wheat Rhizosphere in South Gujarat, India. Environ. Sustain. 2018, 1, 245–252. [Google Scholar] [CrossRef]
- Barker, A.V.; Pilbeam, D.J. Handbook of Plant Nutrition; Taylor and Francis: Boca Raton, FL, USA, 2015. [Google Scholar]
- Merajipoor, M.; Dehnavi, M.M.; Salehi, A.; Yadavi, A. Improving Grain Yield, Water and Nitrogen Use Efficiency of Nigella sativa with Biological and Chemical Nitrogen under Different Irrigation Regimes. Sci. Hortic. 2019, 260, 108869. [Google Scholar] [CrossRef]
- Harmsen, K.; Garabet, S. A Comparison of the Isotope-dilution and the Difference Method for Estimating Fertilizer Nitrogen Recovery Fractions in Crops. III. Experimental. NJAS Wagening. J. Life Sci. 2003, 51, 237–261. [Google Scholar] [CrossRef]
- Das, S.K.; Varma, A. Role of Enzymes in Maintaining Soil Health. Soil Biol. 2010, 22, 25–40. [Google Scholar] [CrossRef]

| Crops | Treatments | Biomass Increase Compared to CF (%) | Economic Yield Increase Compared to CF (%) | Nutrient Uptake (mg seedling−1) | Nutrient Utilization Rate (%) | ||||
|---|---|---|---|---|---|---|---|---|---|
| N | P | K | N | P | K | ||||
| Lettuce | CK | - | - | 59.58 e | 13.93 c | 140.1 d | - | - | - |
| CF | - | - | 148.6 d | 16.21 b | 170.5 c | 23.72 e | 4.18 b | 29.26 c | |
| CF + BI | 11.58 a | 11.30 a | 154.2 c | 18.87 a | 205.0 b | 25.22 d | 9.04 a | 62.50 b | |
| 0.9CF + BI | 7.44 b c | 7.56 b | 164.6 a | 18.82 a | 220.4 a | 31.13 c | 9.95 a | 86.05 a | |
| 0.8CF + BI | 6.93 c | 6.43 c | 168.9 a | 18.14 ab | 217.0 a | 36.45 b | 9.64 a | 92.62 a | |
| 0.7CF + BI | 8.28 b | 7.91 b | 159.2 b | 17.30 ab | 207.3 b | 37.96 a | 8.81 a | 92.53 a | |
| Pepper | CK | - | - | 444.6 d | 125.4 d | 861.7 d | - | - | - |
| CF | - | - | 1468 c | 208.9 c | 1579 c | 68.20 d | 25.50 e | 57.60 e | |
| CF + BI | 19.67 b | 44.55 b | 1853 b | 266.4 b | 1885 b | 93.88 c | 43.06 d | 82.23 d | |
| 0.9CF + BI | 19.16 b | 43.82 b | 1865 b | 264.6 b | 1923 b | 105.22 c | 47.24 c | 94.74 c | |
| 0.8CF + BI | 27.86 a | 63.66 a b | 2158 a | 309.0 a | 2097 a | 142.77 b | 70.07 a | 124.0 a | |
| 0.7CF + BI | 28.04 a | 70.32 a | 2212 a | 271.4 b | 1880 b | 168.35 a | 63.68 b | 116.9 b | |
| Treatments | Lettuce | Pepper | ||||
|---|---|---|---|---|---|---|
| Vc (mg 100 g−1) | Protein (mg g−1) | Soluble Sugar (mg g−1) | Vc (mg 100 g−1) | Protein (mg g−1) | Soluble Sugar (mg g−1) | |
| CK | 23.68 d | 10.88 a | 14.09 a | 72.96 b c | 3.36 d | 16.64 a |
| CF | 22.59 e | 6.57 f | 9.34 c | 59.21 d | 3.89 c | 8.96 d |
| CF + BI | 24.19 d | 9.09 d | 9.57 c | 80.64 a | 6.01 a | 12.58 c |
| 0.9CF + BI | 29.50 a | 8.39 e | 9.28 c | 76.16 a b | 6.00 a | 14.57 b |
| 0.8CF + BI | 27.46 c | 9.65 c | 8.80 c | 71.04 c | 5.46 b | 11.19 c |
| 0.7CF + BI | 28.29 b | 10.27 b | 11.17 b | 78.08 a | 5.29 b | 10.79 c |
| Plants | Treatments | Available Nutrients (mg kg−1) | Protease (U) | Phosphomonoesterase (U) | ||
|---|---|---|---|---|---|---|
| N | P | K | ||||
| Lettuce | CK | 65.89 c | 5.26 d | 50.96 ab | 36.22 b | 0.72 b |
| CF | 65.97 c | 7.74 c | 50.96 ab | 29.06 c | 0.74 b | |
| CF + BI | 65.66 c | 9.30 a | 53.51 a | 40.53 ab | 1.02 a | |
| 0.9CF + BI | 67.02 bc | 9.55 a | 48.42 b | 42.76 ab | 1.12 a | |
| 0.8CF + BI | 69.09 ab | 9.73 a | 50.96 ab | 44.49 a | 1.11 a | |
| 0.7CF + BI | 69.78 a | 8.70 b | 50.12 ab | 45.16 a | 1.13 a | |
| Pepper | CK | 37.35 c | 2.91 d | 26.76 b | 54.89 c | 1.21 c |
| CF | 37.66 bc | 5.91 ab | 29.976 a | 44.06 d | 0.99 d | |
| CF + BI | 38.89 b | 6.06 a | 27.296 b | 60.53 bc | 1.50 b | |
| 0.9CF + BI | 41.74 a | 5.65 b | 27.83 ab | 62.76 ab | 1.54 ab | |
| 0.8CF + BI | 42.15 a | 4.97 c | 27.83 ab | 65.82 ab | 1.61 ab | |
| 0.7CF + BI | 42.54 a | 4.80 c | 23.01 c | 68.16 a | 1.64 a | |
| Index | Lettuce | Pepper | ||||||
|---|---|---|---|---|---|---|---|---|
| Protease | Phosphomonoesterase | SQI | PQI | Protease | Phosphomonoesterase | SQI | PQI | |
| Phosphomonoesterase | 0.785 ** | 0.899 ** | ||||||
| SQI | 0.585 ** | 0.765 ** | 0.627 ** | 0.757 ** | ||||
| PQI | 0.485 * | 0.807 ** | 0.787 ** | 0.544 * | 0.677 ** | 0.963 ** | ||
| PNUI | 0.796 ** | 0.863 ** | 0.792 ** | 0.865 ** | 0.847 ** | 0.845 ** | 0.819 ** | 0.931 ** |
Disclaimer/Publisher’s Note: The statements, opinions and data contained in all publications are solely those of the individual author(s) and contributor(s) and not of MDPI and/or the editor(s). MDPI and/or the editor(s) disclaim responsibility for any injury to people or property resulting from any ideas, methods, instructions or products referred to in the content. |
© 2023 by the authors. Licensee MDPI, Basel, Switzerland. This article is an open access article distributed under the terms and conditions of the Creative Commons Attribution (CC BY) license (https://creativecommons.org/licenses/by/4.0/).
Share and Cite
Chen, D.; Liu, Q.; Zhang, G.; Zang, L. Enhancement of Soil Available Nutrients and Crop Growth in Sustainable Agriculture by a Biocontrol Bacterium Lysobacter enzymogenes LE16: Preliminary Results in Controlled Conditions. Agronomy 2023, 13, 1453. https://doi.org/10.3390/agronomy13061453
Chen D, Liu Q, Zhang G, Zang L. Enhancement of Soil Available Nutrients and Crop Growth in Sustainable Agriculture by a Biocontrol Bacterium Lysobacter enzymogenes LE16: Preliminary Results in Controlled Conditions. Agronomy. 2023; 13(6):1453. https://doi.org/10.3390/agronomy13061453
Chicago/Turabian StyleChen, Danmei, Qingfu Liu, Guangqi Zhang, and Lipeng Zang. 2023. "Enhancement of Soil Available Nutrients and Crop Growth in Sustainable Agriculture by a Biocontrol Bacterium Lysobacter enzymogenes LE16: Preliminary Results in Controlled Conditions" Agronomy 13, no. 6: 1453. https://doi.org/10.3390/agronomy13061453
APA StyleChen, D., Liu, Q., Zhang, G., & Zang, L. (2023). Enhancement of Soil Available Nutrients and Crop Growth in Sustainable Agriculture by a Biocontrol Bacterium Lysobacter enzymogenes LE16: Preliminary Results in Controlled Conditions. Agronomy, 13(6), 1453. https://doi.org/10.3390/agronomy13061453






